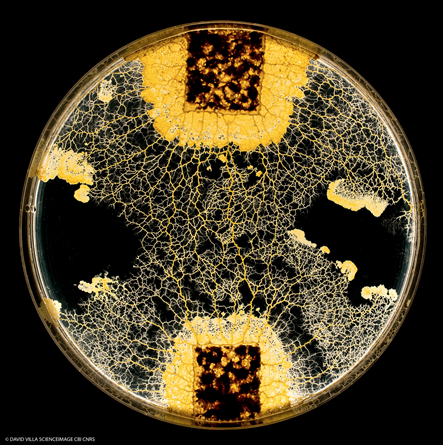

Le blob absorbe les substances pour les mémoriser
En 2016 des scientifiques du CNRS ont démontré que le blob (Physarum polycephalum), un organisme unicellulaire dépourvu de système nerveux, pouvait apprendre à ne plus craindre une substance inoffensive mais aversive et qu’il pouvait transmettre cette connaissance à ses semblables. Dans une nouvelle étude, une équipe du CNRS et de l’Université Toulouse III – Paul Sabatier a montré quel était le support de cette « mémoire » … et il s’agirait en réalité de la substance aversive elle-même ! Ces résultats sont publiés dans une édition spéciale de la revue Philosophical Transaction of the Royal Society B le 22 avril 2019
Le blob est un organisme unicellulaire complexe mais dépourvu de système nerveux. Celui-ci est capable d’emmagasiner une connaissance et de la transmettre à ses congénères mais la manière dont il procède demeurait un mystère. Des chercheuses et chercheurs du Centre de recherches sur la cognition animale (CNRS/UT3 Paul Sabatier)1 viennent de montrer que le blob apprend à tolérer une substance en l’absorbant.
Cette découverte découle d’une observation : les blobs s’échangent de l’information seulement lorsque leurs réseaux veineux fusionnent. Dans ce cas-là, la connaissance circule-t-elle au travers de ces veines ? Dès lors, la substance à laquelle le blob s’habitue constitue-t-elle le support de sa « mémoire » ?
Dans un premier temps l’équipe de scientifiques a entrainé des blobs à traverser des environnements salés pendant six jours dans le but de les habituer au sel. Par la suite, elle a évalué la concentration en sel au sein de ces blobs : ceux-ci en contenaient dix fois plus que les blobs « naïfs ». Les chercheurs les ont alors placés dans un environnement neutre et ont observé qu’ils excrétaient le sel qu’ils contenaient au bout de deux jours, perdant de fait « la mémoire ». Cette expérience semblait donc indiquer un lien entre la concentration de sel au sein de l’organisme et la « mémoire » de l’apprentissage.
Pour aller plus loin et confirmer cette hypothèse, les scientifiques ont introduit dans des blobs naïfs la « mémoire » de l’habituation au sel en en injectant directement dans leurs organismes. Deux heures après, les blobs ne se comportaient plus comme des naïfs mais comme des blobs ayant subi un entrainement de six jours.
Lorsque les conditions environnementales se détériorent, les blobs sont capables d’entrer dans un état de dormance. Les chercheurs ont démontré qu’un mois après être entrés dans cet état, les blobs conservaient leur habituation au sel. Les blobs stockent en effet le sel absorbé pendant la phase de dormance et conservent ainsi la connaissance sur le long terme.
Les résultats de cette étude prouvent que la substance aversive pourrait constituer le support de la « mémoire » du blob. Les chercheurs essayent maintenant de comprendre si le blob peut mémoriser plusieurs substances aversives en même temps et dans quelle mesure il est capable de s’y habituer.
© David Villa / CNRS Photothèque
- 1Le Centre de recherche sur la cognition animale fait partie du Centre de biologie intégrative (CNRS/UT3 Paul Sabatier)
Memory inception and preservation in slime moulds : the quest for a common mechanism. A. Broussard, J. Delescluse, A. Pérez-Escudero et A. Dussutour. Philosophical Transactions of the Royal Society B le 22 avril 2019.


